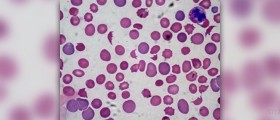

About eyelid dermatitis
Dermatitis is inflammation of the skin caused by many factors. Eyelid dermatitis affects the eyelids. The conditions leads to swelling of the eyelids and itchiness of the affected area. The...

Smoking addiction: why people choose to quit smoking
They say that there is no worse thing than going for acigarette break and then realizing that you did not bring your pack ofhappiness with you. Ouch! But, luckily these...

Revitol skin lightening system - truth about revitol skin lightening cream
RevitolThis text will talk about the Revitol skin lightening system and its efficiency. Most people would like to have toned skin free of all blemishes. The glow seen among the...

Varicose vein pain
Varicose veins are a disorder that mainly appears on the legs and feet even though it can affect any other part of the body. It is a condition marked by...

How to increase appetite
When we are ill, we need all the strength that we can get, since we need to provide our organism with means necessary for fighting the health problem we are...

Herbs for hair
Hail loss, also known as alopecia, can be very traumatic for people, especially if it happens premature or the hair loss becomes excessive. Cosmetic industry uses this common problem and...

Acute soft tissue injury
Soft tissue injury is a fairly common type of injury many people hear about on sports channels or from their friends and acquaintances. What is soft tissue injury?Soft tissue refers...

Uterine ablation facts
Uterine ablation, also called endometrial ablation is a medical procedure performed to destroy or remove the lining of the uterus (the endometrium). This technique is an alternative for hysterectomy. Uterine...

Turmeric for acne
Turmeric is not just a herb used as a remedy for acne and other skin problems. Rather, it is also an important part of cuisine of many countries around the...
Symptoms of being anemic
Anemia is a diseases characterized by a decrease in normal number of red blood cells or (RBCs) or less than the normal quantity of hemoglobin in the blood. Still, it...